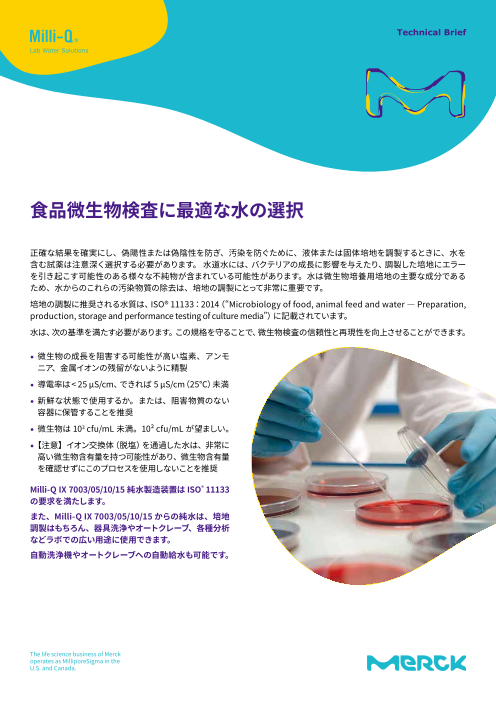

食品・飲料成分分析装置
食品・飲料成分分析装置
32件の登録があります。
食品微生物検査に最適な水の選択
ISO11133の規格と、その基準を満たすメルクの純水製造装置について解説しています。
正確な結果を確実にし、偽陽性または偽陰性を防ぎ、汚染を防ぐために、液体培地や固体培地を調製するときに、水を含む試薬は注意深く選択する必要があります。 水道水には、バク...
食肉・魚肉ソリューション 総合カタログ
当カタログは、フォス・ジャパンが取り扱っている『食肉・魚肉 ソリューション』の全...
簡単かつ高精度な測定ができる「近赤外分析装置」をはじめ、生肉やひき肉、冷蔵、冷凍肉やカートン入り冷凍肉、パレット上の塊肉の測定にも対応した「製造インライン分析装...
FT-IR乳成分分析装置『ミルコスキャンFT3』
バラエティ豊かな乳製品を1台でまとめて測定できる、 FT-IR乳成分分析装置『ミルコス...
自動標準化機能(特許)をはじめ、連続40回のマルチサブサンプリング測定を実現したダブルシリンジシステムや、技術仕様などについて掲載。原料乳の品質検査、乳成分の...
ワイン醸造ソリューション
ワインやアルコール醸造工程における成分分析機器を取り揃えております。まずはご相...
【掲載内容】・FT-IRワイン用成分分析装置 WineScan(TM) ワインスキャン・FT-IRワイン用成分測定装置 OenoFoss(TM) オエノフォス FT-IRユニット OenoFoss(TM) オ...
生乳、乳製品、抗生物質検査ソリューション
原乳から乳加工品まで幅広い成分分析機器を取り揃えております。まずはご相談ください。
【掲載内容】・生乳検査用ソリューション MilkoScan(TM)FT+、Fossomatic(TM)FC・乳、乳製品分析用ソリューション Milkoscan(TM)FT1、Milkoscan(TM)FT2・プロセスソ...
穀物原料・飼料ペレット用水分/容積重計『GAC2500-C』
45%程度までの高水分サンプルでも測定可能!未粉砕のままで高速測定(約10秒)
『GAC2500-C』は、USDA GIPSA(アメリカ農務省穀物検査局)を採用した穀物原料及び飼料ペレット用の高精度水分/容積重計です。サンプル 内部に深く浸透する高周波149mHzを...
食物繊維分析装置『ファイバーテック1023システム』
SDFとIDFを分離可能!使い易く簡単操作の食物繊維分析装置
『ファイバーテック1023システム』は、AOACに記載され、確立されている酵素法に基づく加工食品、穀物食品、飼料、植物原料等の食物繊維の分析を合理的に行うセミオート型定...
試験室における成分測定から研究開発でのご使用まで幅広い業...
『NIRS DS3』は世界で広く普及したNIRS DS2500に測定データの活用によるお客様の業務...
『NIRS DS3』は、全波長領域において、世界最高レベルのスペクトルデータの収集を可能としている近赤外分析計です。モノクロメーターユニットに装着する光源ランプは、...
近赤外分析装置(栄養成分用)『フードスキャン2』
水分・たんぱく質・脂質・塩分・炭水化物など各項目を最短25秒で同時に測定可能!
惣菜や弁当、一般食品の栄養成分表示が2020年4月から義務化されました。効率的な分析手法の一つとして、迅速かつ高精度な栄養成分分析が行える近赤外成分測定装置『フードス...
【大豆粕用】インライン分析装置『ProFoss2』詳細カタログ
インライン型 近赤外成分分析装置『ProFoss2』の大豆粕製品における用途をご紹介して...
『ProFoss2』は、各種製品の製造プロセスにおいて信頼性の高いデータをリアルタイムに分析する、インライン型近赤外成分分析装置です。製造工程をモニタリングすることで...
【バター用】インライン分析装置『ProFoss2』詳細カタログ
インライン型 近赤外成分分析装置『ProFoss2』のバターにおける用途をご紹介していま...
『ProFoss2』は、各種製品の製造プロセスにおいて信頼性の高いデータをリアルタイムに分析する、インライン型近赤外成分分析装置です。製造工程をモニタリングすることで...
【乳製品用】インライン分析装置『ProFoss2』詳細カタログ
インライン型 近赤外成分分析装置『ProFoss2』の乳製品における用途をご紹介していま...
『ProFoss2』は、各種乳製品の製造プロセスにおいて信頼性の高いデータをリアルタイムに分析する、インライン型近赤外成分分析装置です。製造工程をモニタリングすること...
食肉用近赤外成分分析装置『ミートスキャン』
PC内蔵のコンパクト設計!機器の設置場所を問わずご使用いただけます。
『ミートスキャン』は、近赤外分析法により食肉中の脂肪をサンプルの前処理を必要とせず非破壊で迅速かつ高速に測定可能な省スペース型食肉用近成分分析装置です。標準...
ケルテックシステム『ケルダール分析装置 8000シリーズ』
求められる安全性、堅牢性、効率性を高次元で融合致しました!
当製品はケルダール窒素分析における確かな精度と再現性、処理能力、操作性を備えた最新型のケルダール分析装置です。充実した安全装置、センサー類を搭載し、優れた分析...
近赤外分析計『NIRS DA1650』
測定開始ボタンを押すだけの簡単操作!様々な飼料、穀物及び製粉製品を測定
『NIRS DA1650』は、近赤外分析法により、食品、穀物、飼料、粉体製品及びグラスサイレージ、コーンサイレージの品質及び成分を迅速測定するNIRSシリーズの赤外分析計です。...
穀物用近赤外成分測定装置『インフラテックソフィア』
粉砕などの前処理を必要とせず全粒のまま測定可能!
『インフラテックソフィア』は、ダイオードアレイ測定機構を搭載した穀物用近赤外成分測定装置です。堅牢かつコンパクトな本体は携帯性にも優れ、試験室に限らず圃場で...
穀物用近赤外成分測定装置『インフラテックNOVAグレインアナ...
小麦・米や、各種穀物の品質評価に!穀物を粒のまま前処理することなく測定可能
『インフラテックNOVAグレインアナライザー』は、透過光型近赤外分光法により未粉砕穀物の各種成分を高精度に測定します。可視光領域を含めた400-1100nmの低波長域を使用...
粉乳用インライン近赤外成分測定装置『ProFoss2』
当カタログは、粉乳用製造支援ソリューションである『ProFoss2』についてご紹介して...
『ProFoss2』は、製造ラインを流れる粉乳サンプルを連続して分析することにより製造のモニタリング、スプレードライヤーなど製造機器調整の迅速化と最適化、そして分析コス...
乳製品用インライン近赤外成分測定装置『ProFoss2』
当カタログは、新しい乳製品製造支援ソリューションである『ProFoss2』についてご紹...
『ProFoss2』は、製造ラインを流れる乳製品を連続して分析することにより製造のモニタリング、製造機器調整の迅速化と最適化、そして分析コストの削減を実現する新しい乳製...
食肉用インライン近赤外成分測定装置『ProFoss2』
当カタログは、新しい食肉製品製造支援ソリューションである『ProFoss2』についてご...
『ProFoss2』は、製造ラインを流れる食肉製品を連続して分析することにより製造のモニタリング、製造機器調整の迅速化と最適化、そして分析コストの削減を実現する新しい食...
穀物製粉、全粒穀物、なたね粕用 インライン近赤外成分測定装...
当カタログは、新しい穀物製品製造支援ソリューションである『ProFoss2』についてご...
『ProFoss2』は、製造ラインを流れる穀物製品を連続して分析することにより製造のモニタリング、製造機器調整の迅速化と最適化、そして分析コストの削減を実現する新しい穀...
飼料用インライン近赤外成分測定装置『ProFoss2』
当カタログは、新しい飼料製造支援ソリューションである『ProFoss2』についてご紹介...
『ProFoss2』は、製造ラインを流れる飼料を連続して分析することにより製造のモニタリング、製造機器調整の迅速化と最適化、そして分析コストの削減を実現する新しい飼料製...
生乳用細菌数/体細胞数測定装置『バクソマティック』
細菌数及び体細胞数を同時測定!ヒーター内蔵により低温サンプルでも測定可能
『バクソマティック』は、生乳受入現場、生乳検査場における生乳の衛生的乳質検査にお使い頂ける生乳検査ソリューションです。生産者レベルでの乳房炎、衛生状況の管理や...
FT-IR乳成分測定装置『ミルコスキャンマース』
コンパクトなパッケージングに数々の新開発テクノロジーを搭載!
『ミルコスキャンマース』は、生乳 、飲用乳を対象としたFT-IR(フーリエ変換赤外分析)型乳成分測定装置です。最大6成分を約1分で測定できます。また、ホモジナイザー...
FT-IRワイン用成分測定装置『ワインスキャンSO2』
ワイン製造の全工程を通して、最大28項目の成分を同時にかつ高精度に測定!
『ワインスキャンSO2』は、ブドウの収穫時からボトリングまでの全てのプロセスでご利用いただける先端のFT-IR成分分析装置です。収穫前のぶどう糖度のモニターによるアル...
ワイン、マスト用FT-IR成分分析装置『オエノフォス』
測定箇所にサンプルを注入してカバーを閉じるだけの簡単操作!
『オエノフォス』は、ワインの製造工程管理において求められる各種成分項目を、迅速かつ高精度に測定可能なFT-IR(フーリエ変換)成分分析装置です。試薬不要、かつ約2...
ワイン、マスト用FT-IR成分分析装置『オエノフォスGO』
誰でも簡単に3分で測定結果を得ることが可能!
『オエノフォスGO』は、各種品質パラメーターを迅速、簡単かつ高精度に測定するワイン、マスト専用の分析ソリューションです。サンプルを本体にセットして測定開始ボタン...
酸価(AV)油脂劣化度用 簡易油脂検査キットシンプルパック
フライヤー油の交換目安に... 酸価(Acid Value)チェックが簡単に行えます!
油のコスト削減と美味しさの品質管理に!!はっきりとした色の変化だから油交換が誰でも簡単・正確にできます。◆交換目安の酸価値付近を0.5間隔で測定可能◆発色...
AV試験紙(油脂酸価試験紙)
揚げ油の交換管理向け
AV試験紙は“フライヤー油の劣化具合を表す酸価値”を現場で簡単に測定できる試験紙です。◆判定は酸価値1.5、2.5、3.5の3段階で、油の色の影響を受けづらく測定で...
食品衛生管理・分析機器 ダイジェストカタログ
過酸化物価測定、油脂劣化度測定、トランス脂肪酸等の抽出など幅広い製品展開
掲載内容◆衛生管理・残留塩素測定器・簡易水質検査キット・ハンディ水質計 “ アクアブ ”、有効塩素濃度測定キット・パーティクルカウンター◆油脂試験・安全...